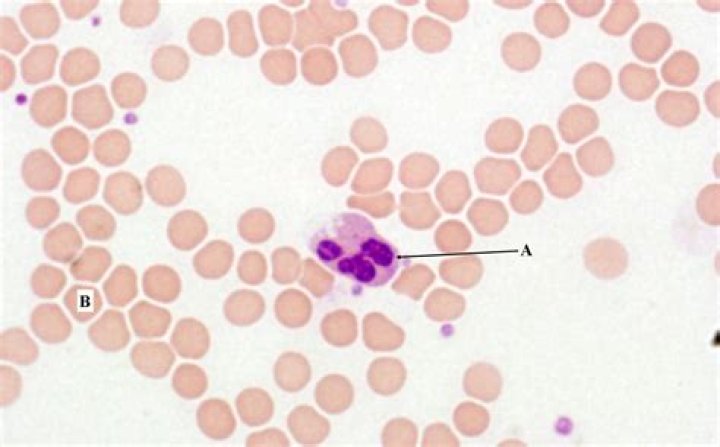

Do eosinophils perform phagocytosis?
 John Hall
John Hall
Eosinophils have bilobed nucleus and make up approximately 2–4% of the WBC population. They are phagocytic and engulf antibody-coated or marked foreign substances. Their primary mode of attack is the exocytosis of toxic compounds, including nitric oxide, and cytotoxic enzymes, onto the surface of their targets.
What cells perform phagocytosis?
However, only a specialized group of cells called professional phagocytes (1) accomplish phagocytosis with high efficiency. Macrophages, neutrophils, monocytes, dendritic cells, and osteoclasts are among these dedicated cells.
Do basophils perform phagocytosis?
Basophils differ from eosinophils and neutrophils in that they are not phagocytes; instead, they degranulate to perform their immune function.
What is the role of the eosinophils?
Eosinophils are white blood cells and part of the immune system that, when working normally, help fight disease and infection. But having too many activated eosinophils may contribute to disease pathology and the self-perpetuating cycle of inflammation and damage across a range of debilitating diseases.
Are eosinophils professional phagocytes?
Professional phagocytes are myeloid cells including macrophages, dendritic cells, neutrophils, monocytes, osteoclasts, and eosinophils. These phagocytes possess specialized cell-surface receptors that allow them to efficiently recognize and degrade particles such as microbes and senescent cells.
Role of phagocytes in innate or nonspecific immunity | NCLEX-RN | Khan Academy
19 related questions foundDo eosinophils have granules?
The presence of large specific granules, also known as secondary granules, is a characteristic feature that distinguishes eosinophils from other granulocytes (neutrophils and basophils). Specific granules consist of a dense crystalline core and a matrix, surrounded by a membrane (5).
Are eosinophils antigen presenting cells?
Eosinophils have been shown to function as antigen-presenting cells (APC) in several experimental allergy model systems (24). Antigen-loaded eosinophils present antigen to primed T cells and increase Th2 cytokine production (12, 31).
Do eosinophils produce immunoglobulin?
Although eosinophils possess immunoglobulin (Ig)G receptors, these are relatively sparse. Instead, the predominant immunoglobulin receptors on the eosinophil surface are high affinity for IgA, consistent with the role of the eosinophil in barrier defense.
What is the role of eosinophils in innate immunity?
Eosinophils are innate immune granulocytes best recognized for their cytotoxic effector functions, causing damage to parasitic pathogens in helminth infections, and to host tissues in allergic diseases.
What do eosinophils release?
Upon activation eosinophils can release an array of inflammatory mediators (Figure 1). Cytotoxic proteins MBP, ECP, EDN and EPO are unique to eosinophils and are important in the defense against extracellular parasitic infections but may also cause excessive tissue damage in allergic conditions.
Why are eosinophils called eosinophils?
The white blood cells shown here (left panel) are eosinophils (nucleus with 2 lobes) and neutrophils (nucleus with 2-5 lobes). The intense pink staining in the eosinophils is the reason why these cells were named "eosinophils", meaning "eosin loving".
What are basophils neutrophils and eosinophils?
There are 5 main types: Neutrophils – main action against bacterial and fungal infections. ... Eosinophils – main action against parasitic infections. Basophils – responsible for responses to allergens. Lymphocytes – main action against viral infections.
Do lymphocytes perform phagocytosis?
Phagocytosis and the immune system
Several types of cells of the immune system perform phagocytosis, such as neutrophils, macrophages, dendritic cells, and B lymphocytes. The act of phagocytizing pathogenic or foreign particles allows cells of the immune system to know what they are fighting against.
Which cell does not undertake phagocytosis?
Complete step by step answer: Basophils are not phagocytic cells. They are granular leukocytes that accumulate at sites of allergy. They fight against parasitic infections and contain heparin which helps in thinning of the blood.
Which organelle is responsible for phagocytosis?
The phagosome is the organelle formed by phagocytosis of material. It then moves toward the centrosome of the phagocyte and is fused with lysosomes, forming a phagolysosome and leading to degradation.
What initiates phagocytosis?
The process of phagocytosis begins with the binding of opsonins (i.e. complement or antibody) and/or specific molecules on the pathogen surface (called pathogen-associated molecular pathogens [PAMPs]) to cell surface receptors on the phagocyte. This causes receptor clustering and triggers phagocytosis.
How do eosinophils recognize antigen?
The eosinophil presents antigens to the Th cell. MHC class II molecules of the eosinophil present antigens to TCR receptors on the Th cell, producing 'Signal 1', and the costimulating molecule CD86 binds to CD28 of the Th cell, serving as 'Signal 2'.
What do eosinophils do to parasites?
Eosinophils kill a variety of helminth parasites and some protozoan parasites in vitro by antibody- or complement-dependent mechanisms. Nevertheless, direct evidence of in vivo parasite killing by eosinophils is scanty.
Do eosinophils produce antibodies?
Eosinophils also are involved in defense against parasites. Eosinophils and antibodies of the immunoglobulin E (IgE) class work together to destroy parasites such as the flatworms that cause schistosomiasis.
Do eosinophils bind IgE?
Thus, patients' eosinophils were able to bind both IgE and IgG in vitro although the amounts of IgE bound in vivo were negligible. FACS analyses of the Ig bound on the eosinophil cell surface and the expression of Fc receptors.
Do mast cells release eosinophils?
The early phase initiates when an allergen activates the tissue resident mast cell, triggering the release of a variety of granule-stored and newly formed mediators. As the inflammatory response progresses, blood borne inflammatory cells--in particular, eosinophils--are recruited into the inflamed tissue.
What is the difference between mast cells and eosinophils?
Mast cells are tissue resident cells and uniquely required for immediate hypersensitivity. Basophils are largely circulating cells, but home to areas of allergic inflammation during the late phase response. Eosinophils are resident to the GI tract, but also home to allergic inflammatory sites.
Are eosinophils innate?
Eosinophils are innate immune leukocytes found in relatively low numbers within the blood.
What is the function of eosinophils and basophils?
Both eosinophils and basophils play active pathogenic roles in the inflammation associated with allergic disorders. Both types of cells share a majority of their cell surface structures, and because of these common surface molecules, both cells can be stimulated with a single ligand simultaneously.
What happens during antigen presentation?
Most often, antigen processing refers to the generation of antigenic peptides from proteins. Antigen presentation refers to the binding of these peptides to MHC molecules and the positioning of the resulting pMHC complexes on a host cell surface so that they can be inspected by T cells.



